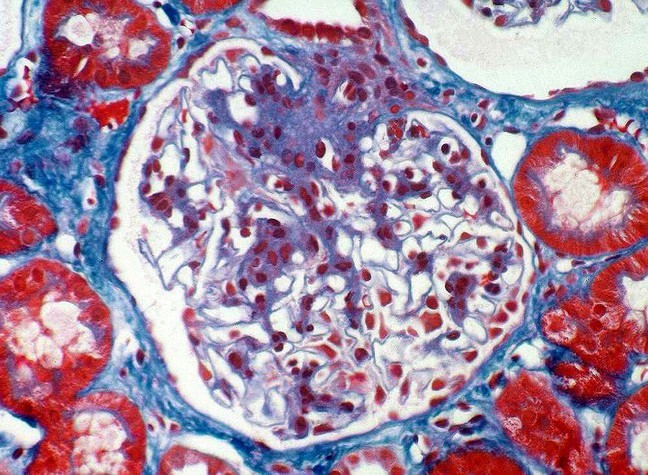

A five year old male is referred for evaluation after his fourth episode of urinary tract infection. Mother received limited antenatal care during pregnancy. Creatinine is normal. Renal ultrasound shows a small echogenic right
kidney with a dilated ureter. Radionucleotide scan shows left kidney contributes 80% of function, right kidney 20%. Based on the kidney biopsy below, what is his diagnosis, prognosis and treatment?

Renal dysplasia
Congenital anomalies of the kidney and urinary tract (CAKUT) due to:
Kidneys are variable in size but most are smaller
Clinical:
Important Contributor to ESRD in children (Especially in bilateral disease)
- In past, thought was that progressive loss of renal function was due to associated collecting system abnormality leading repeated bouts of pyleonephritis
- Modern belief is that parenchymal abnormalities are the cause of progressive decline in renal function
Management:
- Medical prophylaxis of UTI versus surgical correction of collecting system abnormalities
- No convincing evidence that surgery is superior
- Severe reflux with very frequent and/or severe UTI’s is
nevertheless often managed surgically.
- The rate of spontaneous resolution is dependent upon age, grade of reflux, and whether the reflux is unilateral or bilateral.

A 56-year old woman with no significant medical history who presents with 2 months of LE swelling, nocturia and foamy urine. On exam, BP 138/76, periorbital edema, 3+ pitting edema of lower extremities.
Laboratory studies: Cr 1.3, TC 556, Albumin 1.8, Ur Protein: Cr ratio 13, C3 135, C4 38
HIV, HBV, HCV, ANA all negative

Focal segmental glomerulosclerosis:
AKA: Focal Sclerosis
Clinical presentation:
35-40% cases of nephrotic syndrome in adults
- 50% of cases of NS in blacks
- only 20% of nephrotic syndrome cases in children
Clinical course/prognosis:
Two Major Clinical Forms:
Multiple Histologic Subtypes:
Immunofluorescence:
- Trapping of IgM within mesangium
Electron microscopy:
Epithelial Cell Injury
- Foot process fusion
- Detachment from underlying basement membrane
Mesangial Changes
- Fibrosis
- Mesangial Matrix Increase
- Insudative deposition of IgM and C3
- Lipid vacuoles
Genetic predisposition:
- Polymorphisms/mutations in: Nephrin gene, Podocin gene
Injury:
Angio-poietin-like-e–> alters slit diaphragm between podocyte processes–> loss of GBM integrity–> proteinuria
PT is a 56-year old woman with no significant medical history who presents with 2 months of LE swelling, nocturia and foamy urine
On exam, BP 138/76, periorbital edema, 3+ pitting edema of LE
Laboratory studies: Cr 1.3, TC 556, Albumin 1.8, Ur Protein: Cr ratio 13, C3 135, C4 38
HIV, HBV, HCV, ANA all negative
IgM deposition noted in histologic sample below. What is her diagnosis and treatment?

Focal segmental glomerulosclerosis:
AKA: Focal Sclerosis
Clinical presentation:
35-40% cases of nephrotic syndrome in adults
- 50% of cases of NS in blacks
- only 20% of nephrotic syndrome cases in children
Clinical course/prognosis:
Two Major Clinical Forms:
Histology:
Light microscopy:
- Mesangial cell proliferation
- Focal process: not all glomeruli involved
- Segmental process: only tufts involved
- Trichrome stain: expansion of mesangium
Electron microscopy:
Epithelial Cell Injury
- Foot process fusion
- Detachment from underlying basement membrane
Mesangial Changes
- Fibrosis
- Mesangial Matrix Increase
- Insudative deposition of IgM and C3
- Lipid vacuoles
Pathogenesis:
Genetic predisposition:
- Polymorphisms/mutations in: Nephrin gene, Podocin gene
Injury:
Angio-poietin-like-e–> alters slit diaphragm between podocyte processes–> loss of GBM integrity–> proteinuria

MM is a 36 yr old male was noted with new 3+ proteinuria on an insurance physical. History of hypertension.
On exam, he presents with facial edema and elevated blood pressure
3.5gm protein/day on 24 hr urine, SCr 0.8, normal serum complements
Below is a silver stain of a kidney biopsy. What is his diagnosis and treatment?

Membranous glomerulonephropathy:
Clinical course:
Causes:
Immune suppression:

M.S. is a 3yr old boy who presents to the office with generalized edema and abdominal distention
UA – 3+protein, no RBCs
CXR – bilateral pleural effusions
Labs – Albumin 1.2 g/dL, total cholesterol 472 mg/dL, BUN 21 mg/dL, creatinine 1.2 mg/dL
Electron microscopy: below
What is the diagnosis and treatment?

Minimal Change disease:
“Nil” disease= Proteinuria with epithelial cell foot processes fusion
Most common cause of nephrotic syndrome in children
Prognosis:
Pathogenesis:
Treatment: directed at T cells
RW is a 60 yr old male who has been on renal dialysis for the past 15 years. His urinary protein electrophoresis is notable for light chains. Based on his history and the histology below, what is his diagnosis?

Amyloidosis–> Glomerulonephritis:
A collection of diseases sharing a common feature:
- common feature = Extracellular deposition of pathologic insoluble fibrillar proteins
- Protein deposition impairs normal function
Multiple organs and tissues can be involved
Virchow coined the term amyloid, meaning starch like
** Chronic Renal dialysis–> alpha-2-beta globulin deposition
Histo:
Light microscope:
- Amorphous deposition of pink material around glomeruli, afferent, efferent arterioles
- Congo red positive, Not PAS positive
Immunofluorescence:
- Non-specific staining with Ig reagents
Characteristics of protein:
Primary amyloidosis:
Plasma cell dyscrasia with fragment of light chains forming amyloid fibrils
Treatment: chemo +/- bone marrow transplant
Secondary amyloidosis:
chronic inflammatory states (e.g. RA, IBD, CF, psoriasis) with acute phase reactant serum amyloid A forming fibrils
Causes:
Treatment: treat underlying inflammatory disorder

RW is a 60 yr old male who has been on renal dialysis for the past 15 years. His urinary protein electrophoresis is notable for light chains. Based on his history and the histology below (under polarized light), what is his diagnosis?

A collection of diseases sharing a common feature:
- common feature = Extracellular deposition of pathologic insoluble fibrillar proteins
- Protein deposition impairs normal function
Multiple organs and tissues can be involved
Virchow coined the term amyloid, meaning starch like
** Chronic Renal dialysis–> alpha-2-beta globulin deposition
Histo:
Light microscope:
- Amorphous deposition of pink material around glomeruli, afferent, efferent arterioles
- Congo red positive, Not PAS positive
Characteristics of protein:
Primary amyloidosis:
Plasma cell dyscrasia with fragment of light chains forming amyloid fibrils
Treatment: chemo +/- bone marrow transplant
Secondary amyloidosis:
chronic inflammatory states (e.g. RA, IBD, CF, psoriasis) with acute phase reactant serum amyloid A forming fibrils
Causes:
Treatment: treat underlying inflammatory disorder

45-yr old male presents with microscopic hematuria and proteinuria (2 gm/d)
Further evaluation reveals low C3, normal C4 and Hepatitis C viral Ab positivity
Based on the light microscope slide below, what is his diagnosis and treatment?

Membranoproliferative glomerulonephritis: Type 1
Primary and Secondary forms
Immunofluorescence:
- IgG, C3 (low in serum–> ends up in glomerulus), C1q located in subendothelium (vs epithelial)
Electron microscopy:
Treatment:
Treat underlying condition (e.g. HCV)
Idiopathic, nephrotic - Corticosteroids
Antiplatelets? Cyclosporine?
*Relapse is common

A 6-year old child presents to his physician for an annual physical. An opthalmic exam shows small accumulations in his retina. Additionally his urine shows microscopic hematuria and proteinuria. A blood sample taken shows elevated cholesterol. A kidney biopsy is taken (below). Based on his clinical picture and the electron microscope, what is his diagnosis?

Membranoproliferative glomerulonephritis type 2:
dense deposit disease, seen in children. Clinical features:
- Partial lipodystrophy
- Retinal drusen
* Recurs in > 90% of kidney transplants
Histology:
Light microscopy (same as Type 1):
- Small urinary space, enlarged glomerulus
- Lobular proliferation of tuft (vs diffuse in post-strep)
- NO neutrophils (not actively inflammatory)
- PAS stain (glycoproteins): see basement membrane duplication/splitting
Immunofluorescence (same as type 1):
- IgG, C3 (low in serum–> ends up in glomerulus), C1q located in Basement membrane (vs subendothelium)
Electron microscopy:
- band-like dense deposits in basement membrane
A 56 yo woman with a 25 year history of type II diabetes presents to the clinic. She has required insulin for 20 yrs. Eye exam last year was notable for diabetic retinopathy
On exam, 168/102
UA with 3+ protein, Creatinine 2.6
Based on the histologic specimen below, what is her diagnosis and treatment?

Severe Diabetic Nephropathy:
Most common cause of end stage renal disease in the U.S.
Occurs in both Type I and Type II DM
Clinical course:
Early:
- Increased GFR
- Glomerular hypertrophy
- Increased kidney size
- Microalbuminuria
Late:
Pathophys:
Hyperglycemia results in:
- Activated protein kinase C pathway
- Polyol pathway
- Oxygen radical production
- Increase in system wide glycation of proteins
Events due to hyperglycemia cause:
- General accumulation of hyperglycosylated proteins
- Glomerular hypertrophy
- Mesangial expansion
- Basement membrane thickening
- Hyperfiltration injury (related to obesity)
Immunofluorescence:
Electron microscopy:

A 56 yo woman with a 25 year history of type II diabetes presents for an annual physical. She has required insulin for 20 yrs. Eye exam last year was notable for diabetic retinopathy
On exam, BP= 168/102
UA with 3+ protein, Creatinine 2.6
What is her diagnosis and treatment?

Severe Diabetic Nephropathy:
Most common cause of end stage renal disease in the U.S.
Occurs in both Type I and Type II DM
Clinical course:
Early:
- Increased GFR
- Glomerular hypertrophy
- Increased kidney size
- Microalbuminuria
Late:
Pathophys:
Hyperglycemia results in:
- Activated protein kinase C pathway
- Polyol pathway
- Oxygen radical production
- Increase in system wide glycation of proteins
Events due to hyperglycemia cause:
- General accumulation of hyperglycosylated proteins
- Glomerular hypertrophy
- Mesangial expansion
- Basement membrane thickening
- Hyperfiltration injury (related to obesity)
Histo:
Light microscopy:
- Nodular diffuse nephropathy:
- Acellular, PAS, glycosylated proteins deposited in glomerular tuft
- Start in mesangium and spread to rest of glomerulus, compress capillaries

6 year old boy presents with periorbital edema. Parents report URI two weeks ago.
BP : 131/93 mm Hg
Urinalysis with +1 protein, 2+ blood
Based on clinical picture on sample below, what is his diagnosis, prognosis, and treatment?

Post-streptococcal glomerulonephritis
Diagnosis:
Clinical course:
Treatment:
Treatment is supportive only
Dietary sodium restriction
Loop diuretics for edema
Path:
Immune complex mediated disease
**Follow group A beta-Hemolytic Strep infection**
- See elevated antibody titers to strep Ag’s
- Antigenic component not well characterized
- ? endostreptosin or cationic protein related to streptokinase
- Complexes lodge in glomerulus
Immunofluorescence:
- Coarse Granular Pattern
- Capillary wall mainly but some mesangial
IgG and C3
Electron microscopy:

6 year old boy presents with periorbital edema. Parents report recent URI.
BP : 131/93 mm Hg
Urinalysis with +1 protein, 2+ blood
Electron microscope below- what is his diagnosis?

Post-streptococcal glomerulonephritis
Electron microscopy:
MS is an 89 YO woman who presented to the hospital with SOB due to pulmonary edema.
On exam, pitting edema of lower extremities and palpable purpuric rash
Labs with creatinine 3.2 (up from 0.8) and positive serologies for P-ANCA
What is her diagnosis and treatment?

Pauci-immune rapidly progressive glomerulonephritis: Microscopic polyarteritis
FIRST AID:
- Nephritic syndrome= inflammatory; hematuria, RBC casts in urine; azotemia, oliguria, HTN (salt retention), proteinuria (< 3.5 g/day)
- LM/IF: Crescent-moon shaped fibrin, plasma proteins (C3b) with glomerular parietal cells, monocytes, macrophages
- Caused by:
1. Granulomatosis with polyangiitis (Wegener’s)
- c-ANCA
2. Microscopic polyangiitis
- p-ANCA
Poor prognosis: rapid deterioration in renal function (days to weeks)
Treatment: immunosuppression (Cytoxins and steroids) + plasmapheresis in severe renal dysfunction.
Histo:
_Light microscopy:
- Proliferation of crescent-shaped cells compressing glomerular capillaries–> decreased GFR
- Lose nuclei with fibrinous material (necrosis)_
Immunofluorescence:
Electron microscopy:
A 15 year old boy is brought to the emergency department after he begins coughing up blood. Labs reveal traces of blood in his urine as well. A renal biopsy is tagged and reveals the following. What is his diagnosis?

Symptoms: hematuria/hemoptysis

TG is a 25 YO woman with history of SLE complicated by pleural effusions and pericarditis
Referred to nephrology for microscopic hematuria, proteinuria and creatinine 1.7
Below is a histologic specimen from her kidneys. What is her diagnosis and treatment?

Lupus nephritis: Diffuse proliferative glomerulonephritis
FIRST AID:
- Nephritic syndrome= inflammatory; hematuria, RBC casts in urine; azotemia, oliguria, HTN (salt retention), proteinuria (< 3.5 g/day)
- Due to SLE or Membranoproliferative glomerulonephritis
- LM: “wire looping” of capillaries
- EM: subendothelial intramembranous IgG immune complexes, C3 deposition
- IF: granular
** MPGN can present as nephrotic and nephritic syndrome
Activity index:
Chronicity index: predictive of rapid renal decline
Treatment:
Many factors play a role when deciding treatment:
- Pathology (activity and chronicity indexes)
- Symptoms (asymptomatic or full blown nephrotic syndrome)
- Risk factors for worse prognosis (AA race, males, low socioeconomic status, higher creatinine at presentation, high grade proteinuria)
- Compliance
Meds:
Histo:
Lupus nephritis ressembles many diseases–> plastic disease (nothing specific!)
_**Immunofluorescence:
Electron microscopy:
- Presence of Ig detected

35 yr old Asian woman who presents with nocturia and foamy urine. 3 days ago she had a bad cold.
BP: 130/94 mm Hg
Creatinine 0.9, Urinalysis with many RBCs, and few WBCs.
24-hour urine with 1.3 g of protein
Based on the labs and histology below, what is her diagnosis, prognosis, and treatment?

Clinical:
Most common cause of GN worldwide**
- Young age (15-30 years of age)
- Asian**
Variable clinical presentation:
Prognosis:
Histo:
Light microscopy:
Capillary lumens open
Proteinuria generally swells epithelium (not a lot of swelling here)
Too many cells in section of mesangium= mesangial hypercellularity and increase in matrix
= mesangial proliferation
RBCs in mesangial space
Immunofluorescence:
IgA deposition
Electron microscopy:

A 65 year old woman who has been hopitalized for an infection presents with generalized edema 4 days after starting penicillin to treat her infection. Eosinophilia is noted in her CBC. Based on the biopsy specimen below, what is her diagnosis?

Acute interstitial nephritis: Caused by medications
Can become Chronic, especially with long-term analgesic (acetaminophen, NSAID use)
- Patchy interstitial inflammation–> fibrosis, necrosis, scarring of papillae, distorted calices, tubular atrophy
A 6 year old boy presents to the family physician with worsening hearing and vision problems. On physical exam the physician notes swelling in the boy’s feet and ankles. A urine sample reveals hematuria. What is his diagnosis?
Alport syndrome
Conventional (clear cell) Renal cell carcinoma
FIRST AID:
- Origin= PCT cells–> polygonal clear cells filled with accumulated lipids, carbs
Presentation:
- Male, 50-70 years
- Smoker, obese
- Hematuria, palpable mass
- Secondary polycythemia, flank pain, fever, weight loss
- Invades renal vein–> IVC–> hematogenous spread–> mets to bone, lung
* MOST common renal malignancy
• Hereditary cases, like Von Hippel- Lindau (VHL) chromosome 3 (3p) VHL tumor suppressor gene
- Cause paraneoplasic syndrome: ectopic EPO–> polycythemia, ACTH–> cortisol, PTHrP–> hypercalcemia, bone loss
- Silent in retroperitoneum (presents at metastatic stage)
Treatment: resection (if localized), resistant to chemo, radiation
Presentation: – Hematuria
– Few with the classic triad of hematuria, flank pain, and a palpable mass
– Metastasis
– Paraneoplastic syndrome: Hypercalcemia, hypertension, polycythemia (produces EPO)
– Incidental finding (CT or MRI) Risk factor is tobacco smoking
Grossly: Clear cell RCC: well circumscribed, golden yellow, cystic solid, hemorrhagic, necrosis.
Wilm’s tumor= Nephroblastoma
Embryonal tumor from nephrogenic nests
Abdominal mass does not cross midline
Chromosome 11 (11p); WT1 and WT2 genes overexpressed
- 85% of pediatric renal tumors
Associated with dysmorphic tumor syndromes in 10% of the cases:
– Wilms-Aniridia-genital anomaly-retardation syndrome
– Beckwith-Wiedemann syndrome (abdominal wall defect, macroglossia,macrosomia)
– Hemihypertrophy
– Denys-Drash syndrome (pseudohermaphroditism glomerulopathy)
– Familial nephroblastoma
Gross: Large round demarcated tumor with tan-grey, fleshy, hemorrhagic surface
Histo: Mixture of immature renal elements
Hematoxylin-Eosin (H&E stain): Blastema, Stroma and Epithelia.
- Blastema= small blue cells in solid nests.
- Hypocellular stroma with myxoid spindle cells.
- Epithelia arranged in tubules
Transitional cell carincoma:
High Grade Papillary Urothelial Carcinoma (HGPUC)
The most dysplastic
• Frequent mitosis
• Disorganized architecture Nuclear atypia similar to Urothelial Carcinoma In Situ
Clinical features:
Cytogenic abnormalities:
- Deletion of chromosome 9 (9p- or 9q-), 11p, 13p, 14q, or 17p
Risk factors:
Treatment:
TURBT: transurethral resection of bladder tumor;
- Low risk: observe
- Intermediate: chemo, BCG/maintenance
- High risk: BCG/maintenance
* Recurrence–> radical cystectomy
Chemo: Cisplatin
Surgery:
A 32 year old female presents to emergency room with fevers, shaking chills, and flank pain and tenderness. Based on the histology below, what is her diagnosis and treatment? What scenarios would require hospitalization?

Acute pyelonephritis
Path:
Symptoms:
Management:
* Untreated cases can lead to chronic pyelonephritis
1. Complicated Cystitis:
- oral fluoroquinolone such as ciprofloxacin (500 mg orally twice daily or 1000 mg extended release once daily)
- levofloxacin (750 mg orally once daily) for 7 to 14 days.
- Avoid moxifloxacin..
2. Complicated Pyelonephritis — should be managed initially as inpatients. Use broad spectrum antibiotics while awaiting susceptible testing
3. Underlying urinary tract anatomic or functional abnormalities (such as obstruction or neurogenic bladder) should be addressed in consultation with an urologist.
Complications requiring hospitalization:
Diabetes
- Pregnancy
- History of acute pyelonephritis in the past year
- Symptoms for seven or more days before seeking care
- Broad-spectrum antimicrobial resistant uropathogen
- Renal failure
- Urinary tract obstruction
- Presence of an indwelling urethral catheter, stent, nephrostomy tube or urinary diversion
- Recent urinary tract instrumentation, Renal transplantation, Immunosuppression
A 47 year old woman with a history of recurrent UTIs expires in her home. An autopsy is performed that reveals the following in her kidney. What has occurred and what is her diagnosis?

Chronic pyelonephritis
Interstitial fibrosis and atrophy of tubules due to multiple bouts of acute pyelonephritis
Due to vesicoureteral reflux (children) or obstruction (e.g., BPH or cervical carcinoma)
Leads to cortical scarring with blunted calyces; scarring at upper and lower poles is characteristic of vesicoureteral reflux.
Atrophic tubules containing eosinophilic proteinaceous material resemble thyroid follicles (‘thyroidization’ of the kidney); waxy casts may be seen in urine.
Histology: thyroidization, eosinophilic infiltration